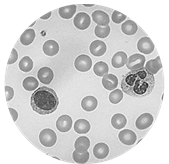

- Банк заданий
- Биология
- Задание 80118
Задание №80118 ЕГЭ по Биологии
Тема : Уровни организации живого
Раздел: Биология как наука
Рассмотрите таблицу «Уровни организации живого» и заполните ячейку, вписав соответствующий термин.
| Уровень организации | Пример |
| Тканевый | ![]() |
| ? | ![]() |